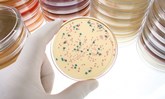
дрожжи в мазке при беременности

Причины жжения при мочеиспускании
На ранних стадиях беременности женщины могут заметить учащенные позывы к мочеиспусканию, что является нормой. В этот период активный обмен веществ и увеличенный приток крови к органам малого таза могут вызывать легкий дискомфорт. В третьем триместре подобные симптомы могут возникать из-за давления плода на мочевой пузырь.
Однако острые боли и жжение в мочеиспускательном канале могут указывать на проблемы с выделительной системой. Возможные диагнозы включают:
- цистит;
- уретрит;
- выход камней или песка из почек (мочекаменная болезнь);
- инфекции мочеполовой системы.
Беременные женщины более подвержены этим заболеваниям из-за снижения активности иммунной системы, что делает организм менее защищенным от инфекций.
Эти заболевания могут угрожать как здоровью женщины, так и будущему ребенку. При появлении симптомов необходимо обратиться к врачу для установления причины.
Расстройства мочеиспускания обычно сопровождаются следующими симптомами:
- жжение и резь в мочеиспускательном канале;
- учащенные позывы;
- ощущение неполного опорожнения мочевого пузыря;
- изменение цвета и прозрачности мочи.
Во время беременности многие женщины сталкиваются с неприятным симптомом — жжением при мочеиспускании. Врачи объясняют это явление несколькими факторами. Во-первых, гормональные изменения, происходящие в организме, могут влиять на работу мочевыводящей системы. Увеличение уровня прогестерона расслабляет мышцы, что может привести к затруднениям в оттоке мочи и, как следствие, к воспалению.
Во-вторых, увеличенная матка оказывает давление на мочевой пузырь, что также может вызывать дискомфорт. Кроме того, беременные женщины более подвержены инфекциям мочевыводящих путей, что может быть причиной жжения. Важно, чтобы женщины не игнорировали этот симптом и обращались к врачу, так как своевременная диагностика и лечение помогут избежать осложнений и сохранить здоровье как матери, так и ребенка.

Цистит
Это заболевание встречается у женщин всех возрастов, особенно часто проявляется во время беременности. Гормональные изменения способствуют проникновению инфекции в мочевой пузырь, вызывая воспаление. Резь и жжение ощущаются в конце или сразу после мочеиспускания. При остром цистите могут наблюдаться повышение температуры и боли в нижней части живота.
Часто во время беременности обостряется хронический цистит, особенно на поздних сроках, когда увеличенная матка давит на мочевой пузырь. Это приводит к застою мочи и создает условия для воспалительного процесса. Запущенная форма заболевания может вызвать пиелонефрит и привести к преждевременным или осложненным родам.
| Причина жжения при мочеиспускании во время беременности | Симптомы | Возможные осложнения |
|---|---|---|
| Инфекция мочевыводящих путей (ИМП) | Частое мочеиспускание, жжение при мочеиспускании, боль внизу живота, мутная или кровянистая моча, неприятный запах мочи | Пиелонефрит (инфекция почек), преждевременные роды, низкий вес при рождении |
| Кандидоз (молочница) влагалища | Зуд, жжение, творожистые выделения | Дискомфорт, возможные осложнения при родах (если не лечить) |
| Вагинит (воспаление влагалища) | Жжение, зуд, выделения, боль при половом акте | Дискомфорт, возможные осложнения при родах (если не лечить) |
| Аллергическая реакция на средства интимной гигиены | Жжение, зуд, покраснение | Дискомфорт, возможно усиление симптомов |
| Дефицит эстрогенов | Сухость влагалища, жжение, дискомфорт | Увеличение риска инфекций |
| Уретрит (воспаление уретры) | Жжение, боль при мочеиспускании, выделения из уретры | Возможные осложнения при родах (если не лечить) |
Мочекаменная болезнь
Дискомфорт и жжение при мочеиспускании могут свидетельствовать о мочекаменной болезни, особенно в период беременности. Выход камней обычно вызывает сильные боли в животе и может привести к появлению крови в моче.
Во время беременности многие женщины сталкиваются с различными изменениями в организме, и жжение при мочеиспускании — одна из распространенных жалоб. Причины этого дискомфорта могут быть разнообразными. Во-первых, гормональные изменения влияют на работу мочевыводящей системы, что может привести к повышенной чувствительности. Во-вторых, увеличенная матка может давить на мочевой пузырь, вызывая неприятные ощущения. Некоторые женщины также отмечают, что изменения в диете и потреблении жидкости могут способствовать возникновению жжения. Важно помнить, что подобные симптомы могут быть связаны и с инфекциями мочевыводящих путей, поэтому при появлении дискомфорта стоит обратиться к врачу. Забота о здоровье в этот период особенно важна, и своевременное обращение за медицинской помощью поможет избежать осложнений.

Уретрит
Жжение при мочеиспускании, вызванное воспалением уретры, ощущается на протяжении всего процесса. В некоторых случаях дискомфорт может быть постоянным, а также возможно незначительное изменение цвета мочи. Без своевременного лечения воспаление может распространиться на мочевой пузырь.
Инфекции
Зуд и жжение в интимной зоне во время беременности могут свидетельствовать о инфекциях мочеполовой системы, таких как кандидоз, хламидиоз, трихомониаз и гонорея. Возбудители этих заболеваний могут проникать на слизистую влагалища и в мочевыводящие пути. Одним из признаков инфекций являются необычные выделения.
Игнорирование заболевания и отсутствие лечения могут привести к воспалению матки и заражению плода. Поэтому при появлении жжения во влагалище важно немедленно обратиться к врачу и пройти анализы.

Лечение нарушений мочеиспускания у беременных
После диагностики заболевания, вызывающего жжение при мочеиспускании у беременной, специалист назначает комплексное лечение. Основное внимание уделяется устранению причины, а не только симптомов.
Медикаменты
Прием лекарств во время беременности может угрожать развитию плода, поэтому выбирать препараты без консультации с врачом не рекомендуется. Обычно лечение включает антибиотики, такие как Амоксициллин, спазмолитики и антисептики, например, Хлоргексидин или Фурацилин. Врач также назначит препараты местного действия, такие как вагинальные свечи.
Фитотерапия
Фитопрепараты, действующие мягко и без противопоказаний, часто рекомендуются беременным женщинам. К ним относятся травяные настои, таблетки и капли. Эти средства положительно влияют на мочевыводящую систему:
- противовоспалительное;
- противомикробное;
- мочегонное;
- спазмолитическое.
Профилактика нарушений мочеиспускания при беременности
Жжение при мочеиспускании у беременных можно предотвратить простыми мерами. Рекомендуется:
- пить достаточное количество воды;
- контролировать рацион;
- выбирать удобное нижнее белье из натуральных тканей, например, хлопка;
- следить за личной гигиеной;
- регулярно опорожнять мочевой пузырь.
Не игнорируйте болезненные ощущения во время беременности, такие как резь или жжение. Своевременное обследование и лечение помогут избежать осложнений и негативных последствий для здоровья малыша.
Вопрос-ответ
Почему при беременности, когда писаешь, больно?
Почему при беременности больно писать? Болезненность при мочеиспускании во время беременности может быть симптомом цистита. Из-за гормональной перестройки и давления растущей матки на мочевой пузырь будущие матери особенно подвержены этой патологии.
Как понять, что у тебя цистит во время беременности?
Симптомы цистита у беременных. Цистит – это инфекция мочевого пузыря, которая проявляется симптоматически. При беременности симптомы цистита такие же, как и в обычное время: внезапное начало частых позывов на мочеиспускание и ощущение неполного опорожнения мочевого пузыря.
Как уретрит влияет на плод?
Недуг может поражать как мужчин, так и женщин. Однако наибольшую опасность уретрит представляет при беременности. Болезнь, диагностированная у женщины во время вынашивания плода, должна быть срочно вылечена. Отказ от терапии или затягивание ее начала может спровоцировать преждевременные роды или выкидыш.
Советы
СОВЕТ №1
Обязательно проконсультируйтесь с врачом, если вы испытываете жжение при мочеиспускании. Это может быть признаком инфекции мочевыводящих путей, которая требует медицинского вмешательства.
СОВЕТ №2
Увлажняйте свой рацион, увеличив потребление воды. Это поможет разбавить мочу и снизить вероятность жжения, а также способствует выведению токсинов из организма.
СОВЕТ №3
Избегайте раздражающих продуктов, таких как острые специи, кофе и алкоголь, которые могут усугубить симптомы. Вместо этого выбирайте более мягкие и питательные продукты.
СОВЕТ №4
Следите за гигиеной и выбирайте удобное, дышащее нижнее белье. Это поможет предотвратить развитие инфекций и снизить дискомфорт во время беременности.